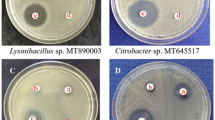

Abstract
Cleaning products containing live bacteria that form spores of Bacillus spp. as active substances are becoming increasingly common in probiotic cleaner formulation. The quality of cleaning performance for the production of probiotic cleaners does not only depend on the potential of the bacterial strains used, but also on the chemical components of the formulations. In this study, the surfactants and other additives were investigated as biocidal or bacteriostatic against B. subtilis, and the viability of B. subtilis was examined at different pH ranges for microbial cleaner formulation. As a result, it was discovered that the B. subtilis, which can be used in the microbial cleaner formulation, shows higher growth and viability at the neutral pH, and it passes into the death phase at pH 3. According to antagonistic activity results, the Gram-positive S. aureus and K. pneumoniae were the most sensitive bacteria while B. cereus was the most resistant bacteria. The anionic surfactants such as linear alkylbenzene sulfonic acid and sodium lauryl ether sulfate act as bacteriostatic on Bacillus spp. and do not cause cell death. In the view of these results, the usage of appropriate bacterial cultures and the correct stabilization of the formulations are also critical elements in the development of microbial cleaner formulations.
Similar content being viewed by others
Explore related subjects
Discover the latest articles, news and stories from top researchers in related subjects.Avoid common mistakes on your manuscript.
Introduction
Nowadays, new-generation cleaning products containing probiotic bacteria or spores as active ingredients attract popular attention. These new-generation cleaning products are also called probiotic cleaners (Teasdale and Kademi 2018; Spöka et al. 2018). The purpose of these new generation probiotic cleaning products was to prevent the development of pathogenic species by tolerating the presence of probiotic species (Vandini et al. 2014). This approach suggesting to replace all pathogens with beneficial bacteria, may be more effective at reducing pollution (Caselli 2017). New-generation probiotic cleaning products contain beneficial probiotic bacteria that can compete with pathogenic species by consuming nutrients on contaminated surfaces. For this reason, these probiotic species are preferred because they remain on the surface where they are applied and prevent colonization and pollution by pathogenic bacteria (Spöka et al. 2018). As a result of researches aiming at the production of probiotic cleaner, it was found that 100% of Bacillus subtilis, 79% of Bacillus amyloliquefaciens, 30% of Bacillus amyloliquefaciens and other Bacillus species were used in the cleaner formulation (Alkaya et al. 2017; Hong et al. 2008; Teasdale and Kademi 2018). The ability of Bacillus species to ferment in the acid, alkaline, and neutral pH ranges, combined with the wide temperature ranges, has led to the development of a variety of biotechnological applications with the desired temperature, pH activity, and stability properties (Schallmey et al. 2004).
To apply an antimicrobial effect, the agent must reach an effective concentration in the biochemical domain. The majority of antimicrobial agents does not affect the outer surface of bacteria. Therefore, the antimicrobial agent must be able to penetrate the bacteria to produce any damage. Gram-positive cells, which lack the additional lipopolysaccharide layer owned by gram-negative bacteria, are more sensitive to many antibacterial agents (Moore 1997; Reygaert 2018). Most of the antibacterial agents disrupt the bacterial cytoplasmic membrane and cell wall. Multiple mechanisms involving permeabilization of the bacterial membrane affect transport processes, intracellular substrate reservoirs, charge gradients, co-factor concentrations, ion gradients and nutrient concentration (Moore 1997). Antibacterial agents cause both bacteriostatic and bactericidal effects. Surfactants have been known to have significant antimicrobial activity for many years (Cowles 1938). Surfactants can be divided into cationic, anionic, amphoteric and nonionic groups. These compounds generally contain carboxylates, sulfonates, sulfates and phosphates as hydrophilic heads. Anionic surfactants are often used in different types of detergents, where the hydrophobic chain for optimum detergent consists of a linear chain of 12–16 carbon atoms (Wieczorek et al. 2018). The antimicrobial activity of surfactants are influenced not only by the chemical properties of surfactants, but also by how the target microorganism grows before and during surfactant treatment (Ishikawa et al. 2002).
Anionic surfactants have a negatively charged head group and the counter ion is usually Na+. This group includes traditional soaps (carboxylates) and the first synthetic detergents: sulfates and sulfonates. Sulphates and sulfonates are more advantageous than carboxylates because they can be used in hard water because they have more tolerance to divalent metal ions (Moore 1997). The bactericidal properties of anionic and cationic detergents were tested against Gram-positive and Gram-negative bacteria and their bactericidal properties were compared by Baker et al. (1941). In their study, it was concluded that anionics are effective only against Gram positive bacteria and are much less effective than cationics.
The alkyl sulfates are a combination of half-esters of sulfuric acid (Cowles 1938). Cowles (1938) examined the bacteriostatic properties of sodium alkyl sulfate with different carbon chain lengths against Gram-negative and Gram-positive bacteria. Linear alkylbenzene sulphonate (LAS) is an anionic surfactant (Ebede and Nwokoye 2019). LAS is a mixture that contains an aromatic ring sulphonated at the para position and attached to a linear alkyl chain (Ebede and Nwokoye 2019). LAS is an anionic surfactant used in detergents, such as laundry powders, dishwashing products and surface cleaner. LAS is a water-soluble, biodegradable and surface active surfactant (Ebede and Nwokoye 2019). The linear alkylbenzene sulfonates (LAS) constitute major group of synthetic surfactants that are used today (Brandt et al. 2001). Cowles (1938) described that the Gram-negative organisms are not prevented from growing by the concentrations of alkyl sulfates used, whereas the Gram-positives, for the most part, are inhibited.
Sodium lauryl sulfate (SLS) is an anionic surfactant. The antimicrobial properties of SLS, alone or in combination with other antimicrobials, against pathogens are well known (Byelashov et al. 2008). The antibacterial action of SLS involves lysis of bacterial cells, denaturation of proteins and enzymes, damage of cell membranes and changes in cell permeability (Byelashov et al. 2008).
Cleaning products contain live bacteria that form spores like Bacillus spp., as active substances (Alkaya et al. 2017; Hong et al. 2008; Teasdale and Kademi 2018). The probiotic cleaning composition also includes one or more type of surfactants or other additives. Surfactants and other additives used in the cleaning composition containing probiotics should not have any negative effects on Bacillus species (Cowles 1938). These optional ingredients should be chosen so that they have little or no negative impact on the Bacillus subtilis (Brooke 2014). In this study, the surfactants and other additives were investigated as biocidal or bacteriostatic against B. subtilis for probiotic cleaner formulation.
Materials and methods
Materials
Nutrient broth (NB), Nutrient agar (NA), Luria–Bertani (LB), Tryptic Soy Agar (TSA) and Tryptic Soy Broth (TSB) were procured from Merck (Merck, Darmstadt, Germany). Polyethylene Glycol (PEG) 40, benzophenone, citric acid, isopropyl alcohol, mono propylene glycol, triethanol amine and nonionic, anionic and amphoteric surfactants were supplied from Hayat Kimya San. A. Ş. (Turkey). In all experiments, deionization water was used. Probiotic Bacillus subtilis ATCC 6633 and Gram positive bacteria Bacillus cereus ATCC 11778 and Staphylococcus aureus ATCC 6538 and Gram negative bacteria Klebsiella pneumoniae ATCC 43816 and Salmonella typhimurium ATCC 14028 were obtained from the culture collection of Algal Biotechnology and Bioprocess Laboratory of Yildiz Technical University (Turkey).
Production of pathogenic bacteria
Stock cultures of Gram positive B. cereus and S. aureus and Gram negative K. pneumoniae and S. typhimurium bacteria were maintained at − 20 °C in nutrient broth (NB) medium, supplemented with 25% (v/v) glycerol. A loopful of the glycerol stock was transferred onto nutrient agar (NA) medium, streaked and incubated at 37 °C for 24 h. Single colonies were inoculated overnight onto nutrient broth (NB) at 37 °C. After that, bacteria were spread on the nutrient agar (NA) plates for antagonistic activity assay (Vandini et al. 2014; Ndlovu et al. 2017).
Production of probiotic bacteria B. subtilis
The B. subtilis ATCC 6633 was maintained in 50% glycerol at − 80 °C. A loopful of the glycerol stock of probiotic bacteria was activated by adding onto Luria Bertani (LB) liquid medium. Then, planting was done on Tryptic Soy Agar (TSA) solid media and Petri dishes were incubated at 37 °C for 24 h. Pure culture was obtained from the colonies grown in TSA Petri dishes. For this, single bacterial colonies were inoculated onto 10 mL LB medium and incubated at 37 °C for 24 h (Ndlovu et al. 2017; Vehapi and Özçimen 2020).
Determining the optimum growth temperature and media for B. subtilis
In this study, the effect of different temperatures (25 ± 2 °C, 30 ± 2 °C and 35 ± 2 °C) and growth media (LB and TSB) on the growth of B. subtilis was investigated. The single colony of B. subtilis was inoculated onto 10 mL LB and TSB liquid medium, and bacteria were incubated at different temperatures such as 25 ± 2, 30 ± 2 and 35 ± 2 °C for 30 h, and the effect of temperature and growth media on bacterial growth was investigated. At regular intervals (e.g. 1 h), the measurements of optical density (OD) of a liquid sample at 600 nm was achieved using spectrophotometer and the optimum temperatures at which the bacteria grew was determined (Vandini et al. 2014; Vehapi and Özçimen 2020).
Growth rates of B. subtilis in buffered media
Bacillus subtilis was incubated at 25 and 30 °C for 30 h at various pH values from pH 3 to 8 in buffered Luria Bertani (LB) liquid nutrient medium and growth curves were obtained by optical density (OD) measurements at regular intervals (e.g. 1 h). The optical density (OD) of a liquid sample was measured at 600 nm using PG Instruments T-60 UV Visible Spectrophotometer device (Vehapi and Özçimen 2020).
Sporulation of B. subtilis
Spores of Bacillus spp. are more resistant to adverse environmental conditions such as high and low temperatures, chemicals and light, because bacteria do not show any metabolic activity. Viable spore counts from spore suspensions were evaluated by colony count after heat treated at 80 °C for 20 min (Nakata 1963; Chen et al. 2010).
Quantification of the microbial load
Counting was performed by preparing 10–5, 10–6 and 10–7 dilutions of the test suspension in diluent buffer (PBS). A sample of 1 mL for each dilution was inoculated in duplicate using the spread plate technique. Each 0.1-mL sample was transferred into separate Petri dishes with 20 mL volume of melted TSA. The number of Colony-forming Units (CFU) was determined by colony counting after incubation of TSA plates at 37 °C for 24 h. The numbers of Bacillus was expressed in CFU mL−1 and the calculation of the microbial load was performed by using the following Eq. (1) (Prabakaran and Balaraman 2006; Vandini et al. 2014):
CFU colony-forming units, DF dilution factor.
The cultures that contain about 1 × 108 CFU mL−1 were centrifuged at 12,000 rpm for 20 min to separate cell mass from the nutrient solution. After that, the cell mass was freeze-dried and stored before use for antagonistic activity assay (Prabakaran and Balaraman 2006).
Antagonistic activity of B. subtilis
Pathogenic bacteria were cultured in nutrient broth (NB) medium and incubated at 37 °C for 24 h. Nutrient agar (NA, 20 mL) was poured into each sterile petri dish (90 mm diameter). Suspensions (100 μL) of pathogenic bacteria cultured for 24 h were spread on the plates. The spores of B. subtilis was freeze-dried and stored before use for antagonistic activity assay. After that, B. subtilis was weighed as 0.01 mg and dissolved with 1 mL of phosphate-buffered saline (PBS), and its antagonistic effect against B. cereus, S. aureus, K. pneumoniae and S. typhimurium species was investigated by disc diffusion method. B. subtilis (30 μL) was directly impregnated into the paper discs (6 mm) of agar plates inoculated with indicator bacteria. The plates were incubated for 24 h at 37 °C, and the rates of the Bacillus spores germination and zone inhibition of pathogenic bacteria were measured in millimeters for 3 days (Lertcanawanichakul and Sawangnop 2008).
Antibacterial effect of surfactants against B. subtilis
The antibacterial effects of surfactants and other additives used for cleaner formulation were determined against B. subtilis probiotic bacteria by agar well diffusion method. 100 µL of bacterial culture of B. subtilis was spread onto pre poured TSA plates (20 mL/plate). After that, 30-µL surfactant solutions were impregnated on agar wells (approximate, 6 mm). Petri plates were incubated at 37 °C for 20 h, the clear zones around well were visually examined, and the thickness of the clear zone around well was measured with a millimeter scale. The analyses were made in three copies and by calculating the average values (Eswaranandam et al. 2004; Vehapi et al. 2020).
Growth rates in liquid batch cultures
The antimicrobial activities of anionic surfactants linear alkylbenzene sulfonic acid (LABSA) and sodium lauryl ether sulfate (SLES) against B. subtilis were determined with respect to treatment time in culture medium (TSB) (Fig. 1). Surfactants at 5 and 10% concentrations were added at 2 h into TSB containing B. subtilis. For this, bacterial cell cultures were inoculated into TSB. After 2 h of inoculation, the surfactants were added onto TSB and at 1-h intervals for 24 h. OD was measured by spectrophotometer and incubated at 37 °C for 24 h. Growth experiments were carried out in sterile 50 mL tube containing 10 mL of newly inoculated TSB growth medium and different concentrations (5 and 10%) of LABSA and SLES. The tube was shaken to resolubilize the surfactant added. Incubation was performed at 37 °C on a rotary shaker (150 rpm), and optical value of samples were taken at regular intervals by UV–Vis spectrophotometer (Brandt et al. 2001; Turchi et al. 2012).
Growth measurement
Optical density (OD) measurement by using spectrophotometer is a common technique that is used for the measurement of an exponential bacterial growth curve in batch culture. The changes in optical density were recorded at 1-h intervals at 600 nm by UV–Vis spectrophotometer. The PG Instrument T-60 UV Visible Spectrophotometer device was used for a optical density analysis. The optical density of the bacteria was measured at specific 1-h intervals for 30 h at 600 nm (Arutchelvan et al. 2006).
Results and discussion
Examination of flask cultivation parameters
In the study, the effect of LB and TSB liquid medium and incubation temperature (25 ± 2, 30 ± 2 and 35 ± 2 °C) on growth of B. subtilis ATCC 6633 was examined (Fig. 2). Flask was 1% (v/v) inoculated and incubated on a rotary shaker 150 rpm for 30 h. The optical density of the B. subtilis was measured at specific intervals for 30 h at 600 nm (Arutchelvan et al. 2006).
According to Fig. 2, when B. subtilis was produced in 35 ± 2 °C TSB liquid medium, it has been observed to show higher growth compared to other temperatures. It was also seen that the lowest growth was achieved at 25 ± 2 °C TSB medium. However, when B. subtilis was produced at 35 ± 2 °C in LB liquid medium, it showed the lowest growth compared to other temperatures.
In addition, when B. subtilis ATCC 6633 was produced onto TSB liquid medium at each different temperature, it has been observed that it shows higher growth than LB liquid medium. As a result, when the growth curve of B. subtilis was examined in Fig. 2, it was observed that B. subtilis showed the highest growth when incubated at 35 °C in TSB growth medium, but it showed the lowest growth when incubated at 35 °C in LB growth medium. In addition, higher growth was achieved when B. subtilis growth at different temperatures such as 25 ± 2, 30 ± 2 and 35 ± 2 °C in TSB medium. However, when incubated at the same temperatures in the LB growth medium, it was observed that it showed a lower growth compared to TSB. In other words, TSB growth medium was observed to be more suitable for the production of B. subtilis ATCC 6633.
Determining the growth rates of B. subtilis to buffered media
The optimum pH range is different for each type of microorganism used in the production of industrial biotechnological products. Therefore, the pH range and strategy of study should be determined specifically for the microorganism and product (Çalık and Özdamar 2002). To examine cell growth at acidic and alkaline pH, B. subtilis was incubated at various pH values from pH 3 to 8 in buffered Luria Bertani (LB) liquid nutrient medium. B. subtilis ATCC 6633 was incubated at 25 and 30 °C for 30 h in buffered LB nutrient medium at pH 3, 5, 6, 7, 8, and growth curves were obtained by Optical density (OD) measurement of bacterial cultures (Vehapi and Özçimen 2020).
Bacillus subtilis cells were incubated at 25 and 30 °C for 30 h at various pH values from pH 3 to 8 in buffered LB nutrient medium and growth curves were obtained. B. subtilis cells at pH 3, 5, 6 and 8 at 25 and 30 °C showed a long lag time (Fig. 3). In addition, it was observed that when the cells were grown at pH 3, 5, 6 and 8, the adaptation phase lasted longer and B. subtilis cells in buffered medium of pH 3 was dead after the adaptation phase. In addition, when the cells were grown at pH 3, 5, 6 and 8, the adaptation phase was observed for the first 4–6 h. On the other hand, when the cells was grown at pH 7, which is the pH value of the medium, it directly adapts to the environment and has passed to the logarithmic phase. After that B. subtilis cells in buffered medium of pH 5, 6 and 8 were grown rapidly similar to control sample pH 7. The highest growth was observed at pH 7 and 8, and the lowest at pH 3 in LB nutrient media at 25 and 30 °C.
A similar lag and dead phases in growth of B. subtilis was observed when cultures were incubated at 35 °C in buffered medium from pH 3 to pH 8 in the study of Vehapi and Özçimen (2020). However, in this study, when the temperature was decreased from 35 to 30 °C and 25 °C, higher growth was observed in all pH values except pH 3 (Fig. 3). Faille et al. (2002), in their study, compared pH 5 and 7 and they observed better growth at pH 7 compared to pH 5. Furthermore, when B. subtilis cells were grown in pH 5, it showed lower growth compared to pH 8. For this reason, it should be noted that anionic surfactants that used in the probiotic cleaner formulation do not prevent the development of B. subtilis cells and do not lower the pH of the cleaner medium (Vehapi and Özçimen 2020).
Spread plate count of B. subtilis
B. subtilis spores are promising probiotics and biocontrol agents, which can be used in plants, animals and humans (Chen et al. 2010). After the sporulation of B. subtilis, the number of spores was evaluated using spread plate method with serial dilution at 10–5, 10–6 and 10–7 with PBS (Table 1). Under optimal conditions, typical cell count for B. subtilis will be in the range of 1.00 × 108 – 1.52 × 1010 CFU mL−1 as obtained using serial dilution and plate count methods (Posada-Uribe et al. 2015). High spore yields values of B. subtilis have been demonstrated in the literature, between 1.00 × 109 spores mL−1 7.40 × 109 spores mL−1 (Luna et al. 2002; Monteiro et al. 2005).
The number of colonies after B. subtilis production at the flask cultivation for 30 h were counted and expressed in CFU mL−1. The number of spores of B. subtilis was obtained as high as 4.30 × 108 CFU mL−1. Vehapi and Özçimen (2020) suggested that they achieved 2.7 × 106 CFU mL−1 of spore under small-scale flask cultivation at 35 °C for 30 h onto LB liquid medium. On the other hand, when B. subtilis was incubated at 25 and 30 °C in this study, we observed that the spore yields of B. subtilis were enhanced to 4.30 × 108 CFU mL−1, because higher growth rate of B. subtilis was achieved at lower temperature onto LB medium (Table 1). Additional data are given in Online Resource Fig. A. Posada-Uribe et al. (2015) suggested that they achieved 1.37 × 109 CFU mL−1 of spore cell density and 93.5% of sporulation efficiency in shake flask production. Chen et al. (2010) observed the spore yields of B. subtilis WHK-Z12 were enhanced to 1.52 ± 0.06 × 1010 and 1.56 ± 0.07 × 1010 spores mL−1 under small-scale flask cultivation and 30 L fermenter fermentation conditions, respectively.
Antagonistic activity of B. subtilis
After obtained 108 CFU mL−1 viable cells from B. subtilis, 0.01 mg weighed and dissolved with 1 mL of phosphate buffered saline (PBS) to adjust at 106 CFU mL−1, and antagonistic effect of B. subtilis cells were examined with agar disc diffusion method against B. cereus, S. aureus, K. pneumoniae and S. typhimurium indicator species (Table 2).
As a result, B. subtilis inhibited indicator B. cereus, S. aureus, K. pneumoniae and S. typhimurium species and showed germination in the environment. Germination of B. subtilis was measured for 3 days (Table 2). Lertcanawanichakul and Sawangnop (2008) suggested that most Bacillus species exhibited inhibitory activity after 72 h of incubation and remained up to the 5th day and they observed that, S. aureus was more sensitive than E. coli. In addition, the most sensitive bacterium in this study was observed as S. aureus and K. pneumoniae with 22.50 and 24.00 mm germination zone of B. subtilis, respectively. It has been observed that B. subtilis continues to germinate as long as it remains in the nutrient medium (Table 2). The results obtained from agar disc diffusion showed that, S. aureus, K. pneumoniae and S. typhimurium were more resistant than B. cereus to probiotic B. subtilis. Lee et al. (2010) suggested that they isolated BSAP-254 from B. subtilis SC-8 and they showed antagonistic activity against gram-positive bacteria B. cereus with inhibition zone smaller than 10 mm.
Antimicrobial activity of surfactant against B. subtilis
Antimicrobial effects of various surfactants and other additives were evaluated against B. subtilis to be used in probiotic-based cleaner formulation. The antimicrobial activity of additives such as, PEG 40 hydrogenated castor oil, benzophenone, citric acid, isopropyl alcohol (IPA), monopropylene glycol, triethanol amine (TEA), and nonionic, anionic and amphoteric surfactants were investigated for probiotic cleaner formulation.
Table 3 shows that growth of B. subtilis was inhibited with anionic, nonionic and amphoteric surfactants but was not inhibited by other additives used for cleaner formulation. Therefore, an “inhibition zone” is measured to determine the susceptibility of microorganism to surfactants. It is then classified as following microorganisms: Resistant (R), Intermediate (I) or Sensitive (S) (Table 3) (Bauer et al. 1966).
Surfactants used in the cleaning composition containing probiotics should not have any adverse effect on B. subtilis (Brooke 2014). The purpose of this study was to determined surfactants for use in formulation of cleaning composition with a lower antimicrobial effect against B. subtilis.
The probiotic cleaning composition may also contain additives. These additives are viscosity modifiers, fragrances, foaming agents, water softening agents, preservatives, stabilizing agents, anionic, cationic, nonionic, amphoteric and zwitterionic surfactants, additional organic solvents for physical stability, sequestering agents (chelating agents), amino carboxylate chelating agents (EDTA and metal salts), carboxylate chelating agents, aromatics and mixtures thereof and coloring agents (Brooke 2014). Citric acid has been used in cleaning products due to its cleaning properties (Kapiloff and Hatch 1985). These optional components should be chosen so that they have little or no negative impact on Bacillus species (Brooke 2014). As a result, it is observed that nonionic surfactants are more compatible with B. subtilis (Table 3). Additional data are given in Online Resource Fig. B.
The bactericidal action of surfactants increases with the number of carbon atoms in the fatty acid, usually highest in those soaps containing 12 or 14 carbon atoms. Cowles (1938) also concluded that for these straight chain alkyl sulphates, there is a relationship between chain length and inhibition against Staphylococcus aureus, and the optimum chain length is between 12 and 16 carbon atoms (Cowles 1938). Birkeland and Steinhaus (1939) was concluded that sodium lauryl sulfate and “Dreft” inhibit the growth of Gram-positive bacteria and molds, but almost all Gram-negative bacteria grow freely. In et al. (2013) described that the growth of S. sonnei was not inhibited by 1–3% citric acid, but the growth of other species S. flexneri, S. boydii and S. dysenteriae was weakly inhibited by > 2% citric acid. Cowles (1938) mentioned that E. coli is able to grow in a concentration of 5% sodium lauryl sulfate.
Effects of LABSA and SLES on growth in liquid cultures
The inhibiting action of varying quantities of the different alkyl sulfates was tried on B. subtilis only. TSB broth was inoculated with single colony B. subtilis culture and after 2 h of incubation 5 and 10% dilutions of the anionic surfactants were added in the same medium (Fig. 4).
So, anionic surfactants (LABSA and SLES) at varying concentrations were added at 2 h into TSB medium that containing B. subtilis. For this, B. subtilis inoculated into tryptic soya broth (TSB), and after 2 h of inoculation (OD = 0.5) the LABSA and SLES surfactants were added onto TSB liquid medium. Results were recorded at 1-h intervals by spectrophotometer at 600 nm for 24-h incubation at 37 °C.
The inhibiting action of varying anionic surfactants was tried on B. subtilis. When cultures were treated with anionic surfactants (LABSA and SLES), exponential growth phase was followed by a stationary phase and cell growth had passed to the stationary phase (Fig. 4). Cowles (1938) has been found that Gram-positive bacteria are generally inhibited by the concentrations of alkyl sulfate used, but Gram-negative bacteria (except two species) are not. In fact, it has been observed that Escherichia coli can withstand much higher concentrations of two surfactants compared to other Gram-negative bacteria (Cowles 1938). Similarly, Birkeland and Steinhaus (1939) investigated the growth inhibitory properties of a wide range of Gram-positive and Gram-negative bacteria of sodium lauryl sulfate (sodium dodecyl sulfate) and the commercial product “Dreft” (containing large amounts of alkyl sulfate). Brandt et al. (2001) described that growth of all four AOB strains was progressively inhibited as the LAS concentration was increased.
In the absence of anionic surfactants, (LABSA and SLES) B. subtilis (control) showed exponential growth from inoculation until the stationary phase was reached after approximately 24 h. On the other hand, anionic surfactant (LABSA and SLES)-treated samples were passed to the stationary phase when the anionic surfactants added to culture medium at 2 h. In this study, bacteriostatic action of sodium lauryl ether sulfate (SLES) and linear alkyl benzene sulfonic acid (LABSA) which have common use as hard surface detergents during the past few years (Cowles 1938; Caselli 2017; D’Accolti et al. 2018; De Cesare et al. 2019) were presented. The B. subtilis also showed immediate, exponential growth until the LABSA and SLES were added to the culture medium. Nevertheless, B. subtilis exhibited growth rates similar to those recorded at all surfactant levels. Also in these strains, the LABSA and SLES addition resulted in complete inhibition of growth or at least in reduced initial growth rates. Cowles (1938) mentioned that Bacillus species such as B. anthracis, B. megatherium, B. mesentericus, B. subtilis and S. aureus was not able to grow in a concentration of 0.1 and 0.03% sodium lauryl sulfate.
Conclusion
As a result, it was observed that the B. subtilis, which can be used in the detergent formulation, shows higher growth and viability at the neutral pH, and it passes into the death phase at pH 3. For this reason, surfactants and other additives used in the probiotic cleaner formulation do not prevent the development of B. subtilis and do not lower the pH of the medium (Vehapi and Özçimen 2020).
The antagonistic effects of B. subtilis against Gram-positive S. aureus and B. cereus and Gram-negative K. pneumoniae and S. typhimurium were evaluated by agar disk diffusion method. The antagonistic activity methods showed that the Gram-positive S. aureus and K. pneumoniae were the most sensitive bacteria while B. cereus was the most resistant bacteria. The antimicrobial compounds, produced by Bacillus strains, have a great potential for controlling the growth of Gram-positive and Gram-negative bacteria (Lertcanawanichakul and Sawangnop 2008; Todorova and Kozhuharova 2010; Moore et al. 2013).
The probiotic cleaning composition also includes one or more nonionic, anionic, cationic, amphoteric and zwitterionic surfactants or mixtures thereof. Surfactants used in the cleaning composition, containing probiotics, should not have any negative effects on Bacillus species (Vehapi and Özçimen 2020). The probiotic cleaning composition can comprise 0.1–35% by weight of anionic and/or nonionic surfactants (Brooke 2014). Anionic surfactants are an amine salt of alkylbenzene sulfonic acid and alkyl ether sulfate (Cowles 1938).
The probiotic cleaning composition may also contain additives. Such additives are viscosity modifiers; fragrances; foaming agents; water softening agents; preservatives; stabilizing agents; additional partners include anionic, cationic, nonionic, amphoteric and zwitterionic surfactants; additional organic solvents for physical stability; sequestration agents (chelating agents); amino carboxylate chelating agents (EDTA and their metal salts); carboxylate chelating agents; aromatic substances and mixtures thereof and coloring agents. These optional ingredients should be chosen so that they have little or no negative impact against Bacillus species (Brooke 2014).
Therefore, it should be concluded that surfactants used in the microbial based cleaner formulation does not prevent the development of B. subtilis and does not lower the pH of the medium (Vehapi and Özçimen 2020). Consequently, the LABSA and SLES may be preferred for the probiotic cleaner formulation due to the fact that they act as bacteriostatic on Bacillus cells and do not cause cell death.
References
Alkaya B, Laleman I, Keceli S, Ozcelik O, Cenk Haytac M, Teughels W (2017) Clinical effects of probiotics containing Bacillus species on gingivitis: a pilot randomized controlled trial. J Periodontal Res 52(3):497–504
Arutchelvan V, Kanakasabai V, Elangovan R, Nagarajan S, Muralikrishnan V (2006) Kinetics of high strength phenol degradation using Bacillus brevis. J Hazard Mater 129(1–3):216–222
Baker Z, Harrison RW, Miller BF (1941) Action of synthetic detergents on the metabolism of bacteria. J Exp Med 73(2):249
Bauer AW, Kirby WM, Sherris JC, Turck M (1966) Antibiotic susceptibility testing by a standardized single disk method. Am J Clin Pathol 45:493–496
Birkeland JM, Steinhaus EA (1939) Selective bacteriostatic action of sodium lauryl sulfate and of “dreft.” Proc Soc Exp Biol Med 40(1):86–88
Brandt KK, Hesselso M, Roslev P, Henriksen K, So J (2001) Toxic effects of linear alkylbenzene sulfonate on metabolic activity, growth rate, and microcolony formation of Nitrosomonas and nitrosospira strains. Appl Environ Microbiol 67(6):2489–2498
Brooke A (2014) U.S. Patent No. 8,801,864. U.S. Patent and Trademark Office, Washington, DC
Byelashov OA, Kendall PA, Belk KE, Scanga JA, Sofos JN (2008) Control of Listeria monocytogenes on vacuum-packaged frankfurters sprayed with lactic acid alone or in combination with sodium lauryl sulfate. J Food Prot 71(4):728–734
Çalık P, Özdamar TH (2002) Bioreaction network flux analysis for industrial microorganisms: a review. Rev Chem Eng 18(6):553–596
Caselli E (2017) Hygiene: microbial strategies to reduce pathogens and drug resistance in clinical settings. Microb Biotechnol 10(5):1079–1083. https://doi.org/10.1111/1751-7915.12755
Chen ZM, Li Q, Liu HM, Yu N, Xie TJ, Yang MY, Chen XD et al (2010) Greater enhancement of Bacillus subtilis spore yields in submerged cultures by optimization of medium composition through statistical experimental designs. Appl Microbiol Biotechnol 85(5):1353–1360
Cowles PB (1938) Alkyl sulfates: their selective bacteriostatic action. Yale J Biol Med 11(1):33
D’Accolti M, Soffritti I, Piffanelli M, Bisi M, Mazzacane S, Caselli E (2018) Efficient removal of hospital pathogens from hard surfaces by a combined use of bacteriophages and probiotics: potential as sanitizing agents. Infect Drug Resist 11:1015–1026
De Cesare A, Caselli E, Lucchi A, Sala C, Parisi A, Manfreda G, Mazzacane S (2019) Impact of a probiotic-based cleaning product on the microbiological profile of broiler litters and chicken caeca microbiota. Poult Sci 98(9):3602–3610
Ebede HN, Nwokoye AOC (2019) Raman scattering and particle distribution studies of zinc oxide nanoparticles capped with linear alkylbenzene sulphonate. IOSR J Appl Chem 12(12):01–07. https://doi.org/10.9790/5736-1212010107
Eswaranandam S, Hettiarachchy NS, Johnson MG (2004) Antimicrobial activity of citric, lactic, malic, or tartaric acids and nisin-incorporated soy protein film against Listeria monocytogenes, Escherichia coli O157: H7, and Salmonella gaminara. J Food Sci 69(3):FMS79–FMS84
Faille C, Membre JM, Kubaczka M, Gavini F (2002) Altered ability of Bacillus cereus spores to grow under unfavorable conditions (presence of nisin, low temperature, acidic pH, presence of NaCl) following heat treatment during sporulation. J Food Prot 65(12):1930–1936
Hong HA, Huang JM, Khaneja R, Hiep LV, Urdaci MC, Cutting SM (2008) The safety of Bacillus subtilis and Bacillus indicus as food probiotics. J Appl Microbiol 105(2):510–520
In YW, Kim JJ, Kim HJ, Oh SW (2013) Antimicrobial activities of acetic acid, citric acid and lactic acid against Shigella species. J Food Saf 33(1):79–85
Ishikawa S, Matsumura Y, Katoh-Kubo K, Tsuchido T (2002) Antibacterial activity of surfactants against Escherichia coli cells is influenced by carbon source and anaerobiosis. J Appl Microbiol 93(2):302–309
Kapiloff AG, Hatch RT (1985) U.S. Patent No. 4,496,470. U.S. Patent and Trademark Office, Washington, DC
Lee NK, Yeo IC, Park JW, Kang BS, Hahm YT (2010) Isolation and characterization of a novel analyte from Bacillus subtilis SC-8 antagonistic to Bacillus cereus. J Biosci Bioeng 110(3):298–303
Lertcanawanichakul M, Sawangnop S (2008) A comparison of two methods used for measuring the antagonistic activity of Bacillus species. Walailak J Sci Technol 5(2):161–171
Luna CL, Mariano RLR, Souto-Maior AM (2002) Production of a biocontrol agent for crucifers black rot disease. Braz J Chem Eng 19:133–140
Monteiro SM, Clemente JJ, Henriques AO, Gomes RJ, Carrondo MJ, Cunha AE (2005) A procedure for high-yield spore production by Bacillus subtilis. Biotechnol Prog 21:1026–1031
Moore SL (1997) The mechanisms of antibacterial action of some nonionic surfactants. Doctoral dissertation, University of Brighton
Moore T, Globa L, Barbaree J, Vodyanoy V, Sorokulova I (2013) Antagonistic activity of Bacillus bacteria against food-borne pathogens. J Probiotics Health 1(3):1–6
Nakata HM (1963) Effect of pH on intermediates produced during growth and sporulation of Bacillus Cereus. J Bacteriol 86:578–579
Ndlovu T, Rautenbach M, Khan S, Khan W (2017) Variants of lipopeptides and glycolipids produced by Bacillus amyloliquefaciens and Pseudomonas aeruginosa cultured in different carbon substrates. AMB Express 7(1):109
Posada-Uribe LF, Romero-Tabarez M, Villegas-Escobar V (2015) Effect of medium components and culture conditions in Bacillus subtilis EA-CB0575 spore production. Bioprocess Biosyst Eng 38(10):1879–1888
Prabakaran G, Balaraman K (2006) Development of a cost-effective medium for the large scale production of Bacillus thuringiensis var israelensis. Biol Control 36:288–292
Reygaert WC (2018) An overview of the antimicrobial resistance mechanisms of bacteria. AIMS Microbiol 4(3):482
Schallmey M, Singh A, Ward OP (2004) Developments in the use of Bacillus species for industrial production. Can J Microbiol 50(1):1–17
Spöka A, Arvanitakisb G, McClung G (2018) Status of microbial based cleaning products in statutory regulations and ecolabelling in Europe, the USA, and Canada. Food Chem Toxicol 116:10–19
Teasdale SM, Kademi A (2018) Quality challenges associated with microbial-based cleaning products from the Industry Perspective. Food Chem Toxicol 116:20–24
Todorova S, Kozhuharova L (2010) Characteristics and antimicrobial activity of Bacillus subtilis strains isolated from soil. World J Microbiol Biotechnol 26(7):1207–1216
Turchi L, Santini T, Beccari E, Di Franco C (2012) Localization of new peptidoglycan at poles in Bacillus mycoides, a member of the Bacillus cereus group. Arch Microbiol 194(10):887–892
Vandini A, Frabetti A, Antonioli P, Platano D, Branchini A, Teresa Camerada M, Lanzoni L, Balboni P, Mazzacane S (2014) Reduction of the microbiological load on hospital surfaces through probiotic-based cleaning procedures: a new strategy to control nosocomial infections. J Microbiol Exp. https://doi.org/10.15406/jmen.2014.01.00027
Vehapi M, Özçimen D (2020) Investigation of B. subtilis viability at different pH ranges for use in microbial cleaner formulation. Bull Biotechnol 1(1):1–7
Vehapi M, Koçer AT, Yılmaz A, Özçimen D (2020) Investigation of the antifungal effect of algal extracts on apple-infecting fungus. Arch Microbiol 202:455–471. https://doi.org/10.1007/s00203-019-01760-7
Wieczorek D, Kwaśniewska D, Chen YL, Shen TL (2018) Antimicrobial activity of sulfobetaine type surfactants. Pol J Commod Sci 1:107–116
Acknowledgements
Meyrem Vehapi is supported by TUBİTAK 2244-Industrial Ph.D. Program no. 118C075.
Author information
Authors and Affiliations
Corresponding author
Ethics declarations
Conflict of interest
The authors declare that no conflicts of interest exist.
Additional information
Communicated by Erko Stackebrandt.
Publisher's Note
Springer Nature remains neutral with regard to jurisdictional claims in published maps and institutional affiliations.
Supplementary Information
Below is the link to the electronic supplementary material.
Rights and permissions
About this article
Cite this article
Vehapi, M., Özçimen, D. Antimicrobial and bacteriostatic activity of surfactants against B. subtilis for microbial cleaner formulation. Arch Microbiol 203, 3389–3397 (2021). https://doi.org/10.1007/s00203-021-02328-0
Received:
Revised:
Accepted:
Published:
Issue Date:
DOI: https://doi.org/10.1007/s00203-021-02328-0